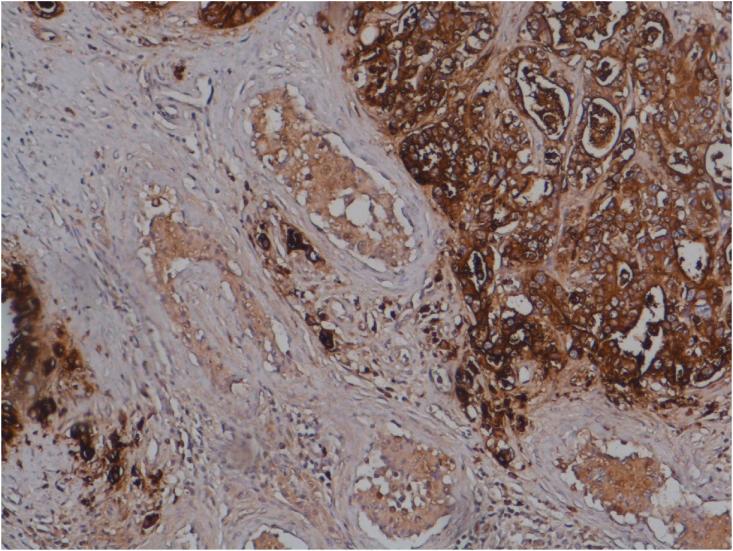

结直肠癌的睾丸转移:一项新观察。
Testicular metastasis of colorectal carcinoma: A new observation.
作者信息
Gabsi A, Mnif A, Adouni O, Mghirbi F, Mokrani A, Mezlini A
机构信息
Department of Medical Oncology, Salah Azaiez Institute, Univsersity Tunis El Manar, Tunis, Tunisia.
Department of Immune-histo-cytology, Salah Azaiez Institute, Univsersity Tunis El Manar, Tunis, Tunisia.
出版信息
Urol Case Rep. 2020 Dec 19;35:101544. doi: 10.1016/j.eucr.2020.101544. eCollection 2021 Mar.
Testicular metastases in colorectal cancer are rare, and pathogenesis still remains unclear. It tends to occur in late stage of disease and has a poor prognosis. We present a 37-year-old patient complained from abdominal pain with deterioration of performance status and weight loss. Body scan showed a recto sigmoid tumor associated with metastasis in the left liver with pelvic lymphadenopathy and hetero nodular testis. Colonoscopy showed a stenosing upper rectum tumor. Histology concluded to an adenocarcinoma. The patient had a transverse colon resection and a right orchiectomy. Histology concluded to an invasive adenocarcinoma with carcinosis, secondary testicular and hepatic metastasis.
结直肠癌的睾丸转移罕见,发病机制仍不清楚。它往往发生在疾病晚期,预后较差。我们报告一名37岁患者,主诉腹痛,身体状况恶化且体重减轻。全身扫描显示乙状结肠直肠肿瘤伴左肝转移、盆腔淋巴结肿大及睾丸异质性结节。结肠镜检查显示上段直肠肿瘤狭窄。组织学诊断为腺癌。患者接受了横结肠切除术和右侧睾丸切除术。组织学诊断为浸润性腺癌伴癌病、继发性睾丸和肝转移。